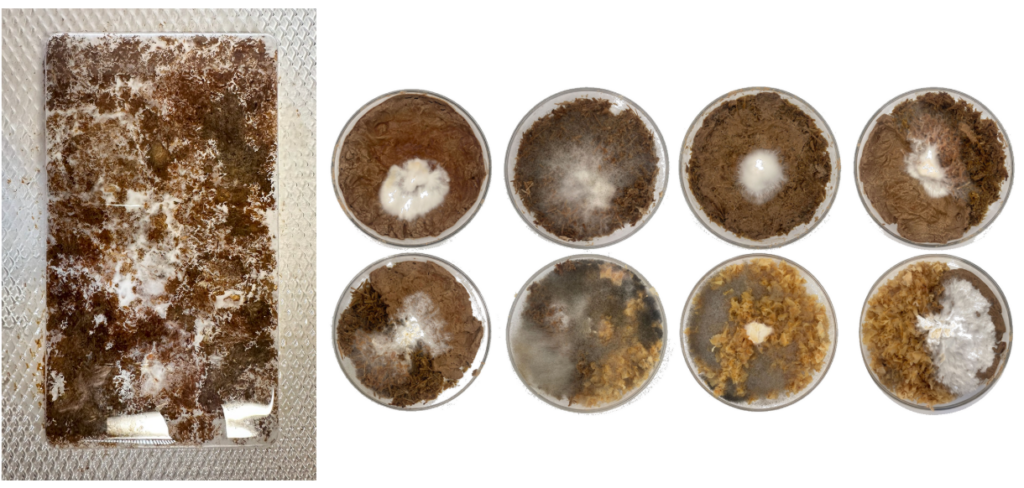

Overview
The Natural Materials Lab at Columbia University is a research platform dedicated to the development and application of natural and low-carbon materials in contemporary architecture.
The lab focuses on materials such as earth, plant fibers, and bio-based composites, investigating how these materials can be integrated into modern design, fabrication, and construction processes.

Rather than treating natural materials as traditional or vernacular remnants, the lab positions them as active components in future building systems—capable of generating new architectural forms, structural logics, and environmental strategies.
Research Leadership

Lola Ben-Alon is an Assistant Professor at Columbia GSAPP, where she directs the Natural Materials Lab and the Building Science and Technology curriculum.
Her research focuses on earth- and bio-based building materials, including their life cycle, fabrication methods, and environmental performance.
She received her Ph.D. from Carnegie Mellon University and holds degrees in Structural Engineering and Construction Management from the Technion, Israel Institute of Technology.
Her work has been widely published and exhibited internationally, contributing to the advancement of sustainable and low-carbon construction research.
Research Focus
Rather than presenting projects individually, the work of the Natural Materials Lab can be understood through a set of interconnected research directions, each demonstrated through selected projects.
1. Designing Material Systems: Earth–Fiber Composites
Projects such as:



- structural behavior
- flexibility
- fabrication potential
Rather than selecting materials after form is defined, these projects suggest a shift toward material system design as a generative process.
2. Fabrication as Form Generation
A central research theme is the integration of fabrication processes into design logic.
Projects including:


explore how:
- additive manufacturing
- digital weaving
- and analog forming techniques
can directly generate geometry and structure.
These works reposition fabrication not as a post-design step, but as a primary driver of form.
3. From Mass to Lightweight and Porous Systems
The lab challenges the conventional perception of earth as a heavy, monolithic material.
Projects such as:


investigate how earth-based materials can be transformed into:
- porous systems
- ventilation structures
- lightweight envelopes
These explorations expand the role of earth from mass construction to environmental and spatial filtering systems.
4. Expanding Material Research Beyond Architecture
Projects include:

These works examine how materials interact with:
- philosophy of nature/culture
- the human body
- environmental systems
This expands architecture into a multi-scalar material ecology, where materials operate across building, body, and environment.
Teaching and Pedagogy

The Natural Materials Lab integrates research with teaching through a series of seminars, workshops, and technical courses at Columbia GSAPP.
Courses such as Making With Earth, Down to Earth, and TECH: Construction and Life Cycle combine theoretical frameworks with hands-on experimentation, allowing students to engage directly with natural materials across multiple scales.
Through material testing, full-scale prototyping, and environmental analysis, the lab promotes a material-driven design approach, where construction, performance, and fabrication are understood as integral to the design process.
Sources
https://www.arch.columbia.edu/research/labs/17-natural-materials-lab
https://lola-ben-alon.com/
Columbia Professor Takes a Down-to-Earth Approach to Building Materials
